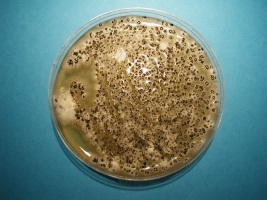

Bakers yeast and Aspergillosis
For those of you who are unfamiliar with the term Aspergillosis, it is “a group of illnesses caused by a certain type of mold. These illnesses usually affect the respiratory system. The mold that triggers the illnesses, aspergillus, occurs widely indoors and outdoors. Most strains of this mold are harmless. But a few can cause serious illnesses when their spores are inhaled by people with a weakened immune system, underlying lung disease or asthma.